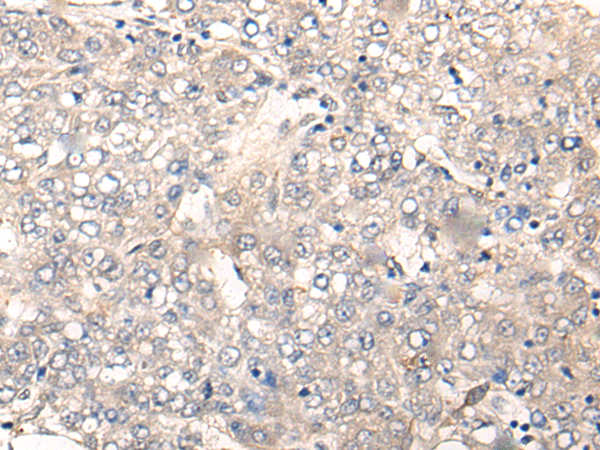

中文名稱: 兔抗NREP多克隆抗體
英文名稱: Anti-NREP rabbit polyclonal antibody
別 名: P311; PTZ17; SEZ17; D4S114; C5orf13; PRO1873
相關(guān)類別: 一抗
儲 存: 冷凍(-20℃)
宿 主: Rabbit
抗 原: NREP
反應(yīng)種屬: Human, Mouse, Rat
標 記 物: Unconjugate
克隆類型: rabbit polyclonal
技術(shù)規(guī)格
|
Background: |
NREP may have roles in neural function. Ectopic expression augments motility of gliomas. Promotes also axonal regeneration. May also have functions in cellular differentiation. Induces differentiation of fibroblast into myofibroblast and myofibroblast ameboid migration. Increases retinoic-acid regulation of lipid-droplet biogenesis. Down-regulates the expression of TGFB1 and TGFB2 but not of TGFB3. May play a role in the regulation of alveolar generation. |
|
Applications: |
ELISA, WB, IHC |
|
Name of antibody: |
NREP |
|
Immunogen: |
Synthetic peptide of human NREP |
|
Full name: |
neuronal regeneration related protein |
|
Synonyms: |
P311; PTZ17; SEZ17; D4S114; C5orf13; PRO1873 |
|
SwissProt: |
Q16612 |
|
ELISA Recommended dilution: |
5000-10000 |
|
IHC positive control: |
Human liver cancer and human esophagus cancer |
|
IHC Recommend dilution: |
20-100 |
|
WB Predicted band size: |
8 kDa |
|
WB Positive control: |
A172 cell and Rat heart tissue lysates |
|
WB Recommended dilution: |
200-1000 |

購物車
購物車 幫助
幫助
 021-54845833/15800441009
021-54845833/15800441009
